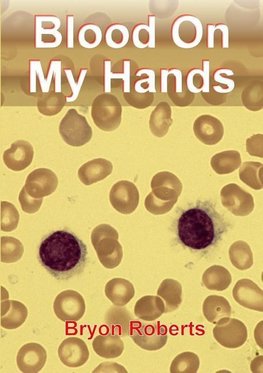
Blood on My Hands

-
 Anglický jazyk
Anglický jazyk
Blood on My Hands
Autor: Bryon Roberts
This is a story of a young doctor who decided to specialise in a discipline, haematology, which did not exist at that time in the NHS. This book describes the difficulty he had in establishing this speciality in Leeds against a myriad of social and political... Viac o knihe
Na objednávku
16.83 €
bežná cena: 18.70 €
O knihe
This is a story of a young doctor who decided to specialise in a discipline, haematology, which did not exist at that time in the NHS. This book describes the difficulty he had in establishing this speciality in Leeds against a myriad of social and political changes over 50 years. There were several interwoven narratives: my training, undergraduate and post graduate; a description of hospital life from the 1950's to the 1990's, and politics both local and national which affected planning and the development of specialties within the hospital. Finally over this time there were a series of momentous developments in biological and medical sciences all of which conspired to make haematology one of the most exciting specialities in the whole of medicine.
- Vydavateľstvo: Lulu.com
- Rok vydania: 2014
- Formát: Paperback
- Rozmer: 210 x 148 mm
- Jazyk: Anglický jazyk
- ISBN: 9781291717679









 Nemecký jazyk
Nemecký jazyk 

